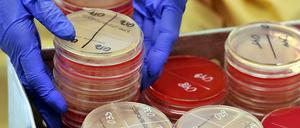
Gefährlich. Ein Patient aus Griechenland trug den multiresistenten Keim KPC ins Uniklinikum Leipzig - und führte zu einem Ausbruch, der zwei Jahre dauerte.

Separatisten berichten, sie hätten vier verschleppte OSZE-Beobachter wieder freigelassen. Die OSZE hat dies bisher nicht bestätigt. Stattdessen meldet die Organisation, sie habe den Kontakt zu einem weiteren Team verloren.

Separatisten berichten, sie hätten vier verschleppte OSZE-Beobachter wieder freigelassen. Die OSZE hat dies bisher nicht bestätigt. Stattdessen meldet die Organisation, sie habe den Kontakt zu einem weiteren Team verloren.

Billiger und schneller zu produzieren und selbst ohne Kühlung in den Tropen haltbar: Gene sollen neue Impfstoffe möglich machen.
60 Elektroautos waren im Kreis auf Tour. Noch sind sie ziemlich teuer

Sind es die glanzlosen braunen Augen, die 80 blassgelben Zähne oder hat seine Lieblingsbeschäftigung – mit offenem Mund herumliegen – dem Stumpfkrokodil seinen Namen gegeben? Ungeklärt.

Michail Bakunin akzeptierte gar keine Herrschaft, auch Karl Marx war ihm zu autoritär. Weshalb der 1814 geborene Revolutionär noch heute T-Shirts von Globalisierungsgegnern ziert.

Das Erbgut menschlicher Keimzellen zu verändern, gilt als Tabu. Nun wird diskutiert, ob solche Eingriffe in Einzelfällen erlaubt werden sollen. Tatsächlich wurde die Grenze in den USA bereits überschritten.
Juraprofessorin Dagmar Coester Waltjen über die gesetzlichen Regeln zur Fortpflanzungsmedizin
Dann fand er diesen Brief aus Schweden: "Ich weiß, dass es Dich gibt"
In der neuen Spielzeit beschäftigt sich das Hans Otto Theater viel mit zerissenen Charakteren. Doch auch im Ensemble selbst gibt es einen kleinen Riss: Elzemarieke de Vos geht,das Jungtalent Denia Nironen kommt.

Die Präsidentschaftswahl steht an - und Russland setzt die Ukraine mit Gasrechnungen weiter unter Druck. 10.000 Menschen sind bereits aus dem umkämpften Osten des Landes geflohen. Nun schickt Merkel eine sanfte Warnung gen Moskau.

90 Künstler arbeiten in den BLO-Ateliers im alten Betriebswerk Lichtenberg. Ob sie bleiben dürfen, ist offen.

Joschka Fischer macht Wahlkampf für die Grünen. Der frühere Außenminister beklagt die Haltung von Teilen der deutschen Linken in der Ukraine-Krise.

Der Name ist eine Frechheit. Wenn zu diesem Tier eine Eigenschaft so gar nicht passt, dann ja wohl: gewöhnlich.

Wer noch nicht draußen war: Ja, es ist auch schon morgens sehr warm. Die Sonne scheint, der Sommer ist da. Das freut nicht nur die Nacktschnecken. Doch gerade Senioren müssen auch aufpassen. Unser Ratgeber.

Was Kreuzfahrtanfänger auf See befürchten – und warum an Bord vieles ganz anders ist.
Das „intersonanzen“-Festival bot vielerlei gegenwärtige Tonschöpfungen und Kompositionen

Beim Velothon in Berlin radelten 8000 Leichtbekleidete durch den strömenden Regen. Von der Umgebung sahen sie nicht viel: Bei Rennrädern ohne Schutzblech spritzt es besonders schön. Aber dennoch waren alle glücklich.

Bei Fürstenwalde im Kreis Oder-Spree wurden gleich zwei Exemplare der weltweit größten Hirschart gesichtet. Experten erwarten noch mehr solcher Kurzbesuche.
Zwei Elchdamen sorgten Anfang der Woche bei Fürstenwalde für einen Stau. Experten erwarten künftig mehr solcher Kurzbesuche.

Sieht so eine ausgestreckte Hand aus? Der russische Eisenbahn-Chef Wladimir Jakunin, ein enger Freund von Kremlchef Putin, attackiert in Berlin den Westen und Homosexuelle.

Woher stammten die ersten Amerikaner? Darüber wird seit Jahren gestritten. Ein 12 000 Jahre altes Skelett aus einer gefluteten Höhle in Mexiko soll den Streit nun befrieden.

Vorsicht im Berufsverkehr: Heute wird es im Norden von Berlin ganz eng. Und die Straße des 17. Juni ist schon gesperrt. Denn Sonntag gehört die Stadt 13.000 Radlern.

Gareth Edwards' „Godzilla“ hinterlässt eine Spur der Zerstörung in Amerikas Städten und übt sich in Aktuellem: Der Film dockt geschickt an das neue Trauma der Reaktorkatastrophe von Fukushima an. Und beglückt zudem die Monster-Nostalgiker.

Vor 37 Jahren erkrankte der letzte Mensch an Pocken, fast ebenso lange währt der Streit, wann die letzten Pocken in den Laboren vernichtet werden sollen. Nächste Woche berät die Weltgesundheitsversammlung erneut darüber. Doch zuvor müssen sich die Verantwortlichen sicher sein, dass wir für den Notfall gewappnet sind, findet unsere Autorin.

Am Sonntag ist Velothon, dann steigen bis zu 15.000 Menschen aufs Rad. Es geht einmal quer durch die Stadt – und für viele raus nach Brandenburg. Für Autofahrer und BVG-Kunden könnte es eng werden auf den Straßen.

Conchita Wurst errang einen symbolischen Sieg für Toleranz und Emanzipation in Europa. Und für Vielfalt. Das Spiel der Geschlechter wirft einen Streit in der Wissenschaft auf. Ist Geschlecht angeboren oder anerzogen?

Die einen tragen ständig neue Geschäftsideen mit sich herum, die anderen setzen sie um. Woran liegt das? An dem viel zitierten Gründer-Gen? Das versuchen Forscher herauszufinden.

Die Evolution hat beim Eisbären vor allem solche Gene verändert, die wichtig sind für Herz und Blutgefäße. Möglicherweise werden so schädliche Effekte der extrem fetthaltigen Ernährung der Tiere verhindert.

Neue Gesetze sollen Experimente stoppen, die Bioterroristen in die Hände spielen könnten. Doch die Pläne werden kritisiert.

Mit Blick auf den einstigen Todesstreifen der Berliner Mauer sinniert unser Kolumnist über die Fußballvereine im Osten. Auch in diesem Jahr bleibt die Bundesliga für sie unerreichbar. Jammern möchte er deswegen aber nicht.

Wann genau Uli Hoeneß ins Gefängnis muss ist noch nicht klar - sicher ist nur: er muss. Die bayerische Häftlingsbetreuerin Gaby Buß erklärt im Tagesspiegel, was den ehemalige FC-Bayern-Chef dort erwartet.

Freunde des gepflegten Jazz kommen wieder auf ihre Kosten. Das Andreas Hofschneider Quartett spielt wieder - jeden Mittwoch im Residenz-Hotel.

Waren und Dienstleistungen für 76 Milliarden Euro tauschten deutsche und russische Unternehmen im Jahr 2013 miteinander aus. Die Krise stellt das nun alles infrage.
Weltweit nehmen sich in jedem Jahr eine Million Menschen das Leben. Auch wenn einzelne Gene bisher noch nicht zweifelsfrei identifiziert wurden, könne man aufgrund bisheriger Studien davon ausgehen, dass die Anfälligkeit für Suizidgedanken etwa zur Hälfte erblich sei.

Mit dem Octavia Green Line haucht Škoda dem Dreiliterauto neues Leben ein – zumindest fast.

Im Nahen Osten breitet sich ein tödliches Virus aus, das vermutlich von Dromedaren stammt. Ein Bonner Forscher versucht herauszufinden, ob der Erreger eine weltweite Seuche auslösen könnte.

Bibiana Beglau gastiert in Dimiter Gotscheffs "Zement" und Frank Castorfs "Reise ans Ende der Nacht" beim Berliner Theatertreffen. Ein Gespräch über Publikumsverachtung und das Spiel für die Einbauküche.

Aus Hautzellen unfruchtbarer Männer züchten Forscher Vorläufer von Samenzellen. Ob das eine Methode für eine Kinderwunschbehandlung sein könnte, ist fraglich - in mehrfacher Hinsicht.
Um sich mit einem multiresistenten Keim zu infizieren, muss man nicht im Krankenhaus liegen. Die Erreger verbreiten sich auch in normalen Haushalten.

Aus Hautzellen einer Diabetikerin haben Forscher erstmals embryonale Stammzellen geklont. Sie sollen zu insulinproduzierenden Beta-Zellen werden. Ein Durchbruch für die Therapie ist das trotzdem nicht.
öffnet in neuem Tab oder Fenster